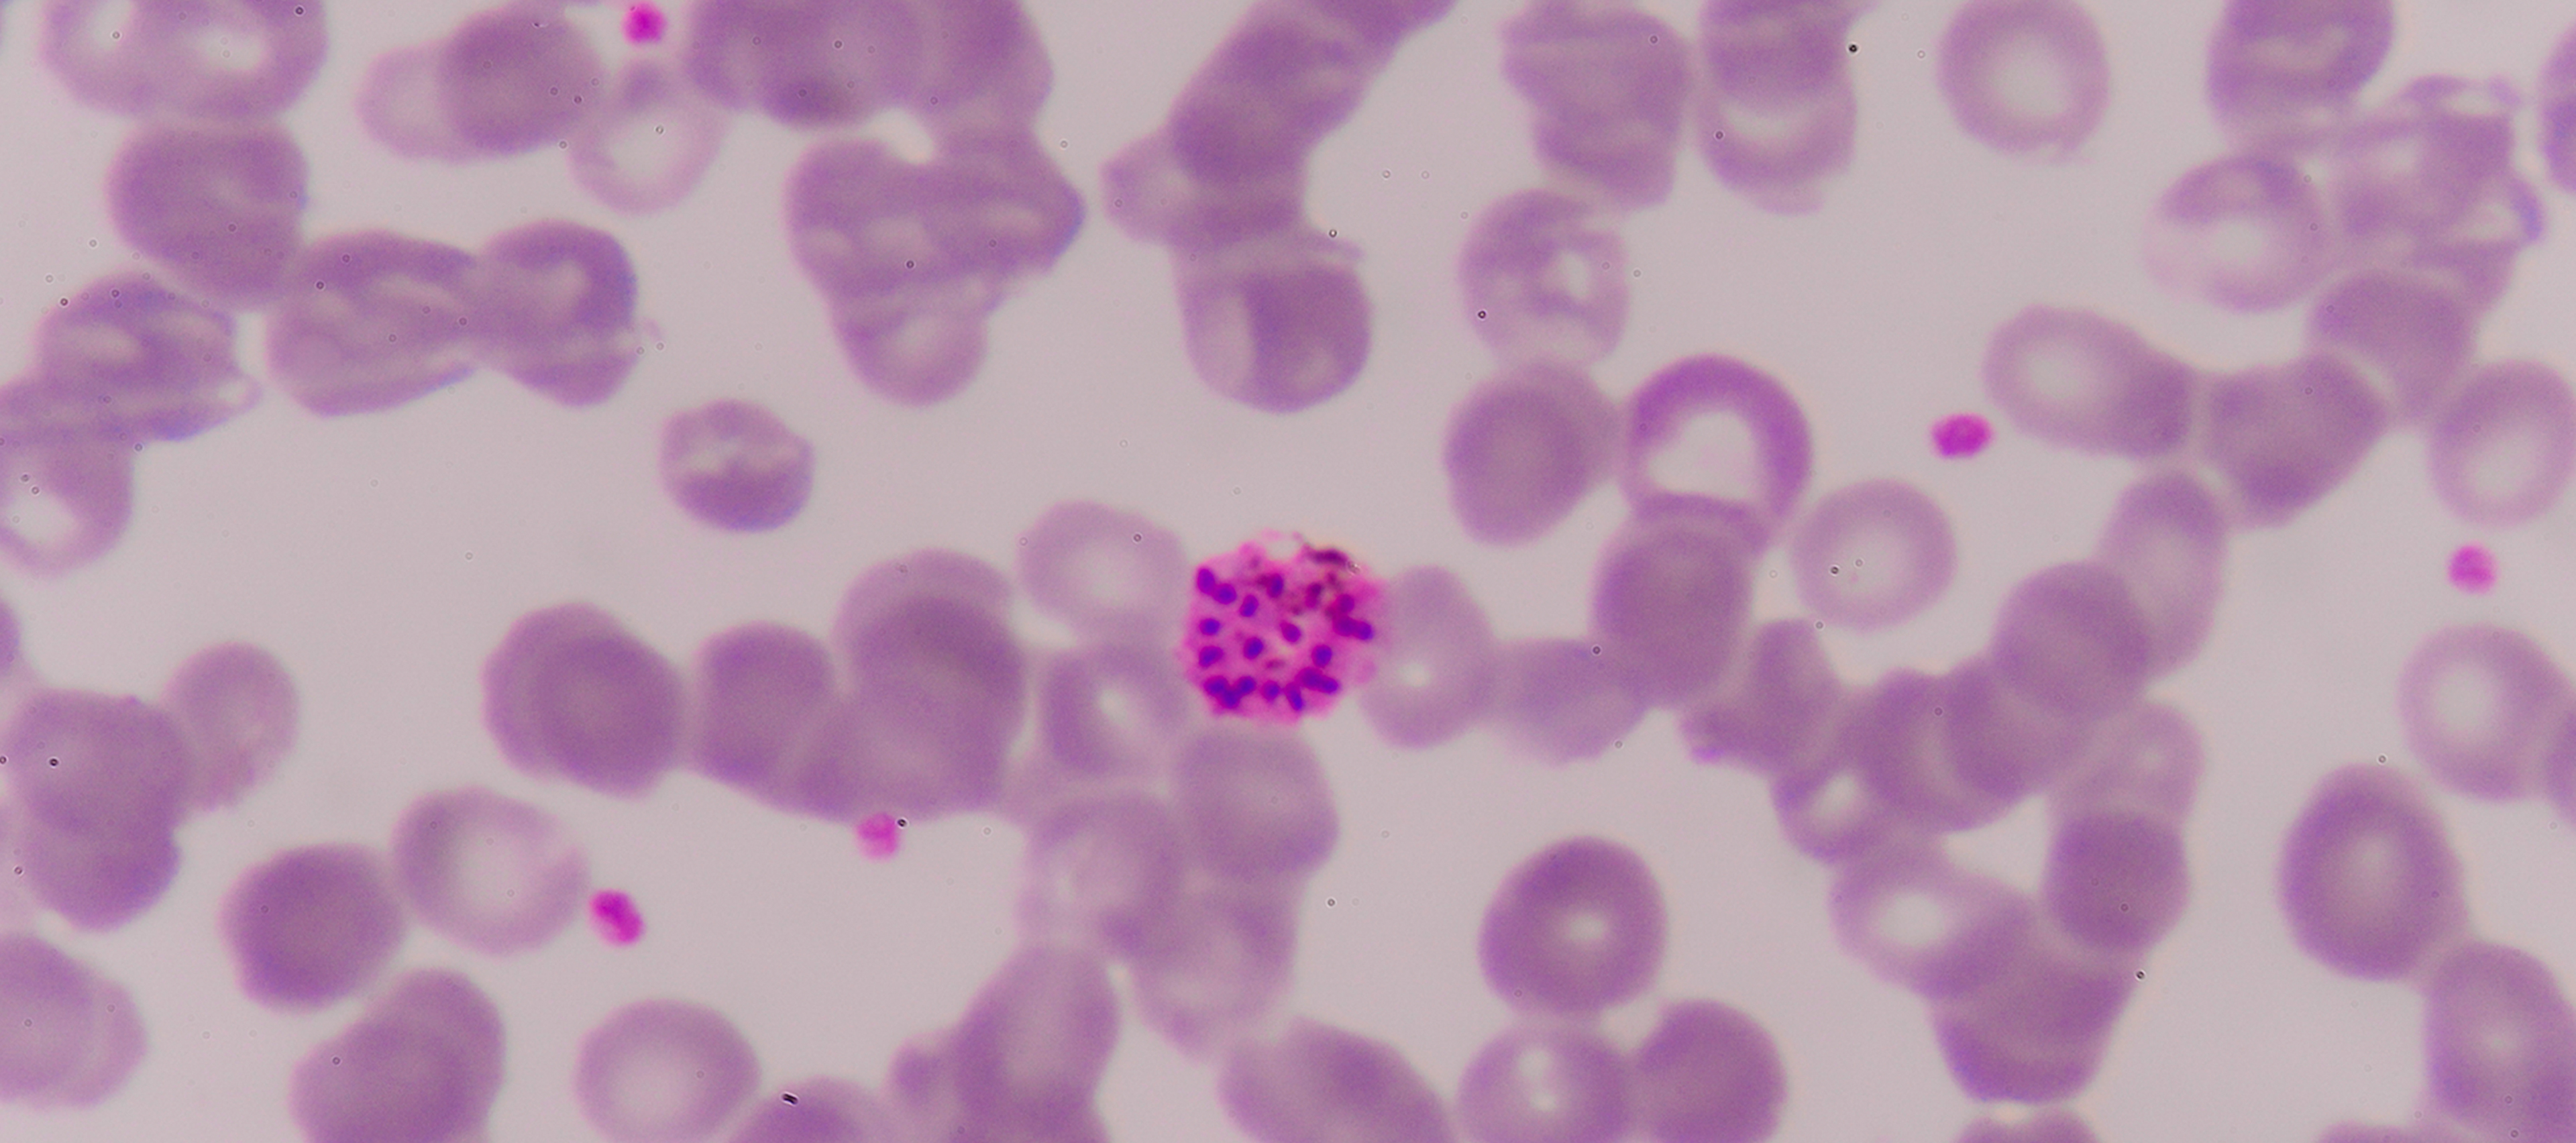
a

Badania mikrobiologiczne
BADANIA MIKROBIOLOGICZNE
Ocena czystości mikrobiologicznej produktów spożywczych, surowców, zgodnie z międzynarodowymi standardami ISO (m.in. ISO 4833-1, ISO 21528-2, ISO 6579-1).
Więcej...
Ocena czystości mikrobiologicznej produktów spożywczych, surowców, zgodnie z międzynarodowymi standardami ISO (m.in. ISO 4833-1, ISO 21528-2, ISO 6579-1).
Więcej...

Ocena biologicznej aktywności i bezpieczeństwa preparatów oraz materiałów na modelach komórkowych, zgodnie z międzynarodowymi normami (m.in. ISO 10993-5:2009).
Więcej...

Badania zawartych m.in. w suplementach diety, żywności specjalnego przeznaczenia medycznego – przeprowadzamy badania skuteczności przeciwdrobnoustrojowej, przeciwzapalnej, proregeneracyjnej oraz antyoksydacyjnej. Oferujemy również analizę mechanizmów działania substancji bioaktywnych na poziomie komórkowym i molekularnym.
Więcej...

Obejmują badania przeprowadzane na modelach zwierzęcych, za zgodą stosownej komisji etycznej, w tym badania bezpieczeństwa preparatów oraz ich wpływu na kształtowanie mikrobiomu.
Więcej...